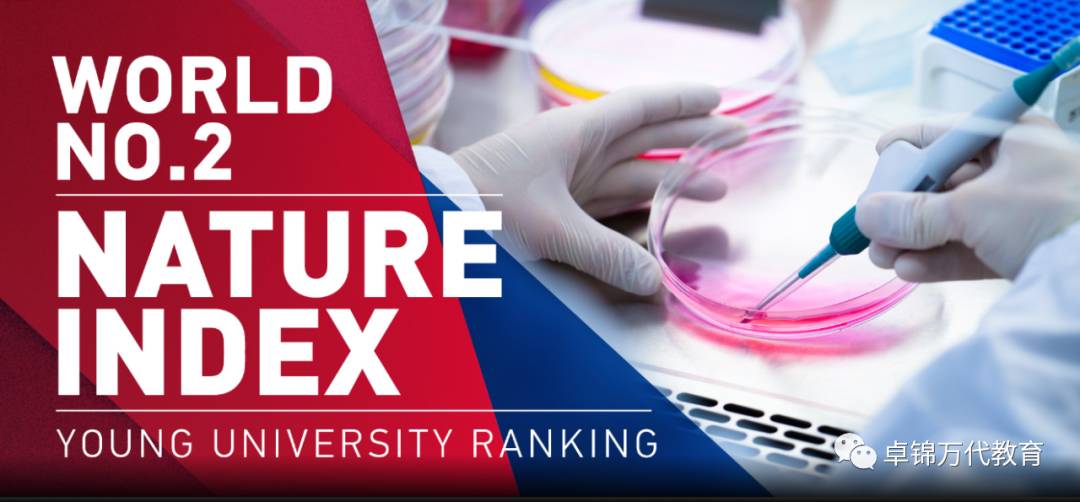
新加坡公立大學及理工學院就業調查

調查 新加坡十大高薪行業
根據東南亞最大的在線職業介紹所-Jobstreet的調查顯示,截至2020年中,前10大招聘的行業是:1,醫療保健 2,教育 3,銀行與金融 4,公務員 5,計算與IT 6,安全與執法 7,運輸與物流 8,建築/建築/工程 9,制造與生産 10,保險。
首先,我們從國際視角看一看新加坡兩所公立大學的就業力情況。新出爐的“2020全球大學就業力排名”是由《泰晤士報高等教育特輯》發布。調查是由法國人力資源機構Emerging設計,來自43個國家和地區的250所大學入榜。各國招聘公司與雇主參與調查,評選哪些大學培養具備傑出工作能力的畢業生。其中,新加坡國立大學,晉升5個名次,名列第9。南洋理工大學躍升18個名次,排名第29。
國大高級常務副校長兼教務長何德華教授,對國大生在這項排名中跻身10大之內表示欣慰:“隨著近期國際形勢顛覆了工作性質,國大正加快步伐培養充滿韌性的畢業生,讓他們掌握精深及跨領域的實際技能與知識,及生活技能等,同時讓他們培養應對全球顛覆性轉變的成長思維。”
南大常務副校長兼教務長林杉教授則說,南大課程符合業界需求,畢業生向來受雇主青睐:“南大接受的高素質教育、所經曆的實習項目,以及海外浸濡及實際生活學習體驗,都讓他們在國際人才競爭方面有更大優勢。南大下來會在課程融入跨學科元素,培養學生對氣候變化和顛覆性科技等國際趨勢,有更好的掌握。”
那麽在新冠疫情的影響下,新加坡大學生的畢業和就業情況到底如何呢。我們繼續看一下今年2月份由新加坡國立大學、南洋理工大學、新加坡管理大學,以及新躍社科大學公布的聯合畢業生就業調查,結果顯示:93.6%的本地大學生在畢業後六個月內找到工作,比前年高出2.9個百分點,但找到全職工的畢業生則爲69.8%,比前年減少近12個百分點。但是,不少畢業生的平均和中位數月薪有所增加。這說明市場對畢業生的需求仍強勁。(注:以下收入單位均爲新加坡元。)
南洋理工大學去年找到全職工的畢業生,平均月收入爲3840元,比前年的3693元增加4%。這批畢業生月薪中位數達3660元,比前年3500元略高。畢業自南大商業及計算學雙學位課程的學生,月薪中位數爲5400元,比前年4833元高,也是去年南大畢業生當中起薪最高的。去年南大畢業生獲得的起薪較前年略增4%,醫學、會計與商科、電腦科學、電腦工程,以及宇航工程專業的畢業生薪金最高。
*爲了適應後冠病時代加速發展的科技世界,南大未來五年的目標之一是培養擁有跨學科技能的人才。從今年8月新學年起,南大將開辦13個跨學科課程。實習將成爲新入學本科生的畢業條件之一,所有新生也須修讀跨學科核心課程,涵蓋的內容包括數碼通識、溝通與提問、道德以及全球挑戰等。
新加坡管理大學畢業生去年的平均和中位數薪金創新高。找到全職工的新大畢業生,平均月薪爲4196元,比前年的4121元增高。去年找到全職工的新大畢業生,月薪中位數則是3900元,比前年3800元多。從事金融與保險業的新大畢業生,起薪仍然是最高的,平均總月入爲5187元。
新躍社科大學畢業生去年整體就業率爲94%,比前年增加4.6個百分點。躍大去年找到全職工的畢業生,平均和中位數起薪,分別爲3238元和3000元。金融理學士課程畢業生去年的起薪表現最強勁,平均月薪就達3854元,是該大學畢業生當中最高。
耶魯—新加坡國立大學學院(Yale—NUS)去年共有187名畢業生,147人參與調查。就業調查顯示,耶魯—國大學生畢業後投入的行業相當廣泛,包括信息與通訊科技、公共服務、金融、教育,以及科學及工業研究。去年畢業的學生,超過九成在六個月內找到工作,他們的月薪中位數達4038元,比前年高出6.3%。其中全職理學士榮譽學位畢業生的起薪爲5350元,文學士榮譽學位畢業生的起薪則達3890元,對比前年,增幅分別爲7%和5.6%。
根據新加坡理工大學針對畢業生所做的初步調查,截至去年底,91%畢業生已找到工作,包括部分時間等性質的工作。由于各課程結業的時期不同,具體的就業調查有待公布。2019年的就業調查顯示,新工大畢業生有近91%在半年內就業,其中84%從事全職工作。超過55%在畢業前獲得實習公司的工作聘約。月薪中位數從2015年的3000元增至2019年的3500元。
新工大自2009年成立以來便強調應用學習,通過綜合學術職場培訓計劃,讓學生汲取實際的工作經驗。獨特的教育模式讓學生享有良好的就業前景。新工大畢業生的就業情況與其他大學如新加坡國立大學、南洋理工大學相近。新工大爲各領域栽培不少傑出畢業生,已能與其他大學平起平坐。它目前提供的本科生與研究生課程超過40項,每年錄取約2900名新生,收生人數在各大學中屬第三多。接下來,新工大也將加強跨學科學習,計劃爲15%至20%的課程注入跨學科內容。今年的畢業生當中有211名是修讀綜合保健類課程的首屆學生。新加坡理工大學是本地第一所提供放射診斷、職能治療、放射治療與物理治療大學課程的學府。
新加坡五所理工學院
2020年有11909名學生理工學生畢業,當中的8946人接受調查,占總數約75%。截至2020年10月1日,也就是期末考試後約六個月,回應調查的畢業生有56.4%已就業,另有42.9%表示正在或准備升學,高于前年的38.9%。
2017年畢業後完成國民服役的男畢業生有5461人回應調查,其中42.3%已就業,另有57.2%表示正在或准備升學。這些學生是從2019年4月1日至2020年3月31日之間服完兵役。
調查顯示,畢業後半年內找到工作的畢業生占87.4%,低于2019年的90.7%,以及2018年的89.5%。從事全職工作的畢業生占有52%,低于2019年的61.1%,以及2018年的59%。
從事兼職或臨時工的畢業生占31.6%,高于2019年的25.5%,也高于2018年的26.4%。他們當中約半數反映他們同時在升學或有意升學,這與過去幾年的情況相同。未就業的畢業生占12.6%,高于2019年的9.3%,低于2018年的12.6%。當中有2.9%表示已找到工作或准備創業,接下來將開工。
2020年理工學院畢業生全職工作的月薪中位數維持在2400元,與前年相同,也高于2018年的2350元。整體而言,工程、衛生科學,以及信息與數碼科技類課程的畢業生月薪中位數過去三年比其他課程的畢業生高。
衛生科學課程畢業生的月薪中位數2020年依然是各課程類別當中最高的,達2553元。衛生科學類課程包括:護理、藥劑科學、視光學等。信息與數碼科技類,以及人文與社會科學課程畢業生的月薪中位數則有2500元。
最後,以下文結束今天的內容,或許從中可以感受新加坡大學的成功之處:
新加坡大學跨學科教育培育T型人才
讓大學生像刺猬也像狐狸
本文源自《聯合早報》
高等教育應培養“專才”或“通才”?近幾年在社會上和學界一直被廣泛討論,當中也興起“刺猬”與“狐狸”的對比。英國哲學家以賽亞·伯林(Isaiah Berlin)撰寫的《刺猬與狐狸》把人歸爲兩類,一種是知道一件重要大事的“刺猬”;另一種則是融合多元想法和經驗的“狐狸”。
新加坡國立大學校長陳永財最近在一篇評論中指出,世界快速轉變,只專注學習一個學科不足夠,畢業生須能融合跨學科知識,解決棘手問題。
國大希望培養具備“刺猬”與“狐狸”這兩類素質的畢業生。專才與博學要如何並存相濟?
本期《實況報道》訪問大學、學者、學生,以及人力資源專家,探討大學本科教育走向跨學科的必要。
跨學科教學以不同的規模和形式在本地大學行之有年,但面對後冠病時代,高等教育學府如今來到必須思考如何讓這個模式更普及化的關鍵時刻。受訪的本地大學主管指出,跨學科教育不是在“專”與“博”之間做取舍,而是做到專博兼備。這是爲了讓學生在專長的領域有紮實基礎,同時拓展對不同學科知識的廣度,以便在快速轉變的職場能觸類旁通、有效解決問題。
約兩個月前,新加坡國立大學在網站公布,有意集合文學暨社會科學院,以及理學院兩個院系的強項,設立人文與理學院(College of Humanities and Sciences),進一步提升跨學科教育。國大目前仍就設立人文與理學院的計劃進行咨詢。新學院一旦成立,預計最快可在2021學年收生。
國大:著重爲課程注入更大靈活性
擬議中的新學院將開拓學習的廣度,學生通過共同課程(common curriculum),有機會接觸人文、社會科學、科學探究與亞洲學知識,掌握語言和批判思考等能力。學生在選科方面也享有更大靈活度。國大于20多年前開始爲個別學習項目的學生進行跨學科教學,如今准備以更大的規模來落實這個教學方式。
國大校長陳永財在9月和10月先後于《海峽時報》和《聯合早報》發表的評論《大學須拆掉學科孤島》中指出,畢業生未來面對的挑戰,超越單一學科的解決方案,需要他們融合跨學科的知識來克服。
對國大來說,要讓學生接觸更多知識面,意味著學生的課業負擔得調整,包括放寬對主修課程的過度要求,以便在整體課程上增加廣度。國大同時朝向解題式教學和體驗式學習的方向發展。但陳永財強調,這並不表示學生的核心技能或學術水平會降低,國大並非要在專業和通用之間做出取舍,重點是要爲課程注入更大的靈活性。
本地部分大學的課程受美式教育模式影響,從一開始就融入跨學科和多學科教學元素。
以新加坡管理大學來說,本科生必修的核心課程(core curriculum)是跨學科教育的其中一個體現,這是學生在主修科以外須完成的通識教育。新大教務長柯莫西教授(Timothy Clark)說,核心課程去年8月更新後,學生在大一和大二修讀一系列課程,廣泛接觸不同學科知識,能與下來主修科的學習相輔相成。柯莫西不認爲跨學科教學會犧牲學習的深度。他強調,主修科的內容知識是分不同階段來傳授,好讓學生有時間從不同學科汲取知識,再應用在主修科的學習上。“跨學科教學讓學生在思考或面對某個問題時,會從不同學科的角度去探討。這種看到不同事物之間的連接的能力,有助學生建構更深刻的知識基礎。學生培養的創新和實用技能也能應用在各個行業。”
新加坡科技設計大學的課程雖以科技和設計思維爲主軸,但學生也必須學習社會科學和人文科目,以及人工智能或數據科學等。新科大校長張道昌教授說,跨學科教學所要培養的“T型人才”,指的是在某個領域有深厚基礎,同時又具備幾項不同學科的知識技能。“這能讓他們對各種想法保持開放,觸類旁通,有效解決問題。”
剛畢業自新加坡科技設計大學工程系統與設計課程的盧建安(24歲),目前在美國面簿公司擔任軟件工程師,畢業前已被錄取。他認爲,他的課程融入設計思維,又讓他廣泛涉獵不同學科,有助于目前的工作。“我們要怎麽利用所學來設計一個解決方案?這需要設計思維,新科大因此非常重視這一塊。第一年也要求學生學習不同科目,例如物理、化學和數學等。一些學生可能會覺得,沒必要學習這些內容,尤其當它們與主修學科無關聯。但我喜歡這樣的教學理念,這能讓學生通過廣泛接觸,建立一定知識基礎,未來能靈活地根據不同的問題開發解決方案,培養工程師的設計思維。”
“解題式學習”助學生整合不同知識
跨學科學習不僅是累積不同學科知識,本地大學力求通過“解題式學習”課程設計,幫助學生對不同知識進行整合,對某一課題的不同面向,有更深刻了解。從明年新學年起,南洋理工大學入學新生都須修讀一套共同課程,加強跨學科知識,如數碼技能、創新及溝通等技巧。課程占學習內容的五分之一。
南大躍大擬爲課程加強跨學科元素
南大常務副校長兼教務長林杉教授說,共同課程包含探討全球宏觀挑戰的單元課。“不同院系學科的學生會組團隊,一起進行學習項目,探討解決複雜問題。走出學科專業的舒適圈,學生思維會鍛煉得更靈活。”林杉說,南大下來會探討開辦新的跨學科和多學科課程,並會加強現有雙學位和雙主修課程的跨學科元素。
新躍社科大學發言人說,躍大從一開始就強調多學科學習及應用型教育,本科必修的核心課程讓學生涉獵人文和社會科學,並要求他們展開實踐項目,學以致用。明年起,躍大會提升部分研究生課程的跨學科元素,修讀社會科學碩士學位課程的學生,須完成兩項畢業文憑(Graduate Diploma)課程,並且要整合及應用兩個學科的知識,進行一項研究項目。
同樣側重應用學習的新加坡理工大學,雖不像其他公立大學開辦通識課,或提供副修或雙主修,但跨學科教學已融入課程設計,學生須掌握對他們主修專業領域有深刻影響的學科知識,會計課程學生修讀數據分析是一例。新工大副校長(學術)兼教務長蔡其昌教授說,新工大有意讓跨學科學生進行整合式研究項目(capstone project)。“這會同實際工作環境相似,團隊成員貢獻各自的知識,對業界實際問題探討方案。”
至于擬議中的國大人文與理學院,其共同基礎課程占學生學習內容的三分之一,並包含融合不同學科和研究方法的單元課。國大高級常務副校長兼教務長何德華教授說,跨學科教學會透過整合幾個不同學科的視角和方法,讓學生解決某一個課題或挑戰。“我們的最終目的是培養畢業生在跨領域團隊中有效、無障礙地協作。”
專家:跨學科知識應與主修專業相關
對于跨學科訓練能否讓畢業生求職更占優勢,人力資源公司仁立國際執行董事梁昌國說,雇主重視的是員工的技能與經驗,以及靈活應變的學習態度。如果跨學科教學能提升解決問題和跨領域協助能力,讓畢業生一開工就可以進入狀況,相信能爲他們增值。然而,他認爲,跨學科教學終究要回歸務實,大學設計這類課程,讓學生接觸的不同學科,應同他們的主修專業有一定相關性。
亞鷹人力資源公司總裁葉慧蓮認爲,加強跨學科教育有助學生開拓新視野與點子,日後能受用,畢竟疫情突顯有利于職場生存的特質,就包括勇于創新和嘗試新事物。
人文科目被邊緣化?
學者:關鍵在課程設計
提倡跨學科教學,培養學生解決實際問題的能力,人文科會否因“不夠實用”而不受重視?學者認爲,這取決于決策者如何設計課程,課程若能更好地讓學生看到不同學科之間的連接,文科還是會占據重要位置。
消息公布引發網絡議論,不少人質疑理科背景學生修讀人文科系的實用性,也有人關注人文學科會否在跨學科教育中被邊緣化。新加坡國立教育學院副教授陳英泰博士認爲,如果看從一開始就參照美式教育模式的學府如新大的核心課程,甚至耶魯—國大學院的博雅教育,不難發現人文科並沒被輕視。“課程設計者如何考量是關鍵。他們希望開拓學生哪方面的知識?哪些學科是無論什麽專業或將來投入什麽行業的學生都應知道,因此必修?哪些又可選修?這些不是簡單抉擇。”
但陳英泰相信,若要學生更全面了解世界,人文科在跨學科課程中必占一席之地。
放眼國際,著名學府不乏橫跨文理學科的例子。以英國倫敦大學學院爲例,它在2012年推出文科與理學學士學位課程,主修人文類學科如曆史、文學的學生必須副修理工科;主修衛生與環境類,或理工科的學生得副修人文或社會科學。主修和副修科占一半課時,學生其余時間修讀核心單元,這可包括跨學科研究法、外語、量化法,以及實習等。
以上內容主要整合自《聯合早報》。